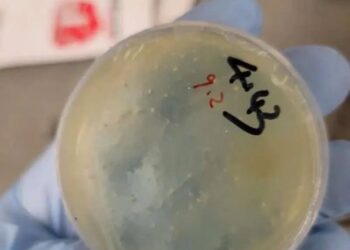
Plato de Petri con material biológico.

Tercer científico chino arrestado después de contrabandear ‘patógenos biológicos’ en Wuhan después de la investigación del ‘agroterismo’
A un tercer científico chino ha sido acusado por presuntamente contrabandear el "material biológico" en los Estados Unidos.Es el segundo...
Leer másDetails